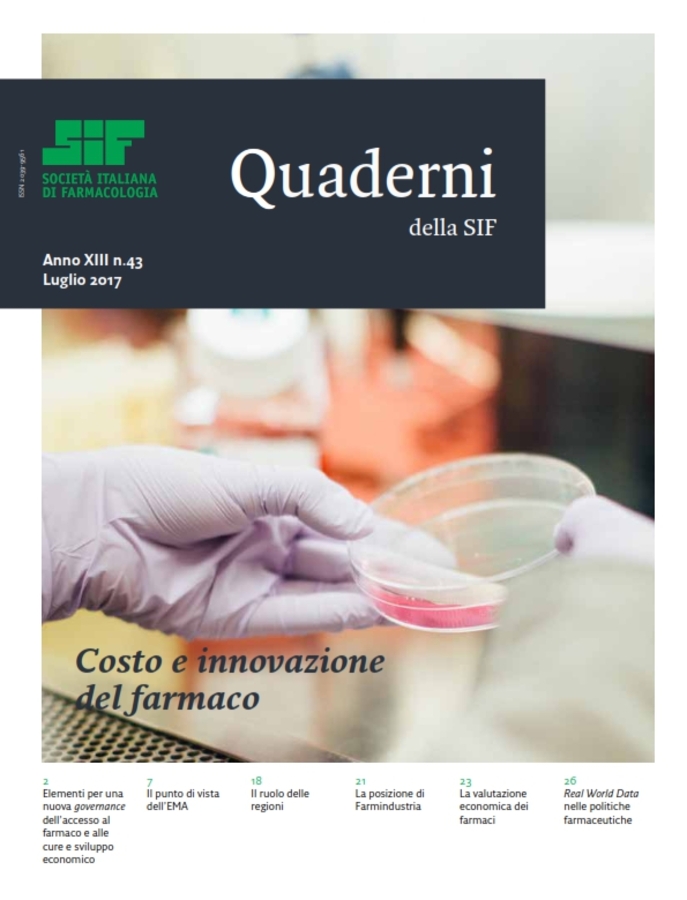
sif-Quaderni della SIF-43

La Società Italiana di Farmacologia è tra i beneficiari dei proventi del 5 per mille dell’IRPEF.
IL VERSAMENTO DEL 5 PER MILLE ALLA SIF SARÀ DESTINATO ESCLUSIVAMENTE A FINANZIARE BORSE DI STUDIO E PREMI
È sufficiente apporre la propria firma ed indicare, sulla dichiarazione dei redditi, nel riquadro associazioni di volontariato, onlus, associazioni di promozione sociale e da altre fondazioni e associazioni riconosciute, il Codice Fiscale della SIF che è 97053420150, per destinare tali fondi a Borse di studio SIF per giovani ricercatori.
Per informazioni:
Segreteria SIF: +39-02-29520311
e-mail: segreteria@sifweb.org